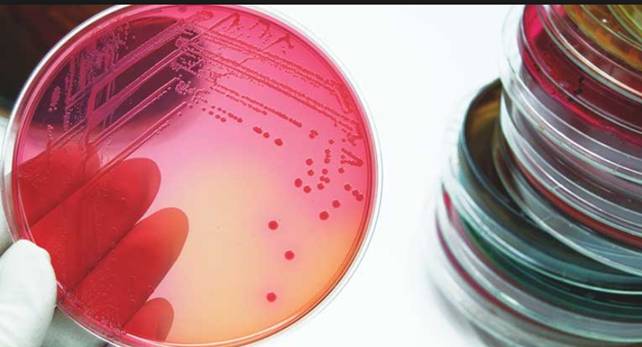

Escherichia coli là một loại vi khuẩn gram âm, kỵ khí không bắt buộc, vi khuẩn có hình roi (Gram-negative facultatively anaerobic rods) thường tìm thấy bên trong phần dưới của ruột của các động vật máu nóng. Chúng thường không gây bệnh, nhưng một số chủng có thể gây nên tiêu chảy và nhiễm trùng sinh mủ (pyogenic infections). Các chủng gây bệnh được phân loại bởi cơ chế sinh bệnh đặc biệt (specific pathogenic mechanisms) như các độ tố chẳng hạn.
Escherichia coli, vi khuẩn đại tràng là tên gọi chung dùng để chỉ các loại vi khuẩn gram âm có trong đường ruột. Hầu hết chúng đều không gây hại và được xem là một phần của hệ vi khuẩn đường ruột. Tuy nhiên một số loại như Shigella spp, Salmonella spp., Yersinia pestis lại tỏ ra cực kì nguy hiểm và chúng có thể sản sinh ra chất độc gây ra nhiều bệnh tật khi xâm nhập vào trong cơ thể. Khi quan sát dưới kính hiển vi, các nhà nghiên cứu nhận thấy rằng vi khuẩn E coli có hình que, chiều dài của chúng dao động từ 1 μm đến 5 μm. Loại vi khuẩn này rất kị khí và có thể lên men chuyển hóa đường thành acid lactic. Hầu hết các loại vi khuẩn E coli đều có khả năng nitrat thành nitrit. Một số loài có thể di chuyển bằng roi, một số ít thì ở yên một chỗ không có khả năng di động. Chúng không thể tạo bào tử như nhiều loại vi khuẩn khác. Tất cả mọi người đều có nguy cơ bị nhiễm vi khuẩn E. coli vì các nguyên nhân sau:
(i) Uống nước bị ô nhiễm: Ở một số vùng nông thôn, người dân vẫn còn thói quen sử dụng nước từ giếng khoan hoặc từ sông, suối, ao, hồ trong nấu nướng và sinh hoạt hàng ngày… Đây chính là nguồn lây nhiễm vi khuẩn E.coli cao nhất. Ngay cả ở các thành phố lớn nếu nguồn nước máy cung cấp không được xử lý tốt vẫn có thể gây bùng phát một đợt dịch bệnh do nhiễm vi khuẩn E.coli sau khi người dân sử dụng nguồn nước bị ô nhiễm;
(ii) Ăn uống không đảm bảo vệ sinh: Vi khuẩn E.coli có thể còn tồn tại trong các thức ăn chưa được nấu chín, sữa không tiệt trùng, nước trái cây hoặc rau củ quả tươi. Khi chúng ta ăn những loại thực phẩm này vào thì rất dễ bị nhiễm bệnh;
(iii) Lây truyền từ người sang người: Chẳng hạn như những người bị nhiễm bệnh làm việc trong nhà hàng và không rửa tay đúng cách sau khi đi vệ sinh có thể lây truyền bệnh cho khách hàng và các nhân viên khác;
(iv) Tiếp xúc với động vật nhiễm mầm bệnh: Vi khuẩn E.coli có thể lây lan trong các trang trại, các vườn thú và hội chợ. Đặc biệt khi chúng ta tiếp xúc với thú cưng trong nhà bị nhiễm bệnh thì có nguy cơ bị nhiễm vi khuẩn E.coli rất cao;
(v) Sức đề kháng kém, bị giảm acit dạ dày: Trẻ em, người cao tuổi, những người phẫu thuật dạ dày hoặc đang dùng thuốc giảm axit dạ dày là những đối tượng dễ bị nhiễm khuẩn vì lý do này.

Hình 1
Một số triệu chứng khi nhiễm khuẩn đường ruột E.coli
Triệu chứng nhiễm E. coli thường xuất hiện 3-4 ngày sau khi tiếp xúc với vi khuẩn. Tuy nhiên, các triệu chứng có thể xuất hiện sớm nhất là 24 giờ hoặc muộn nhất là 1 tuần sau đó. Chúng ta không nên bỏ qua những dấu hiệu sau:
·Đau bụng hoặc co cứng bụng trầm trọng. Cơn đau thường kéo đến một cách đột ngột không bào trước
·Tiêu chảy nước, bắt đầu một vài giờ sau khi cơn đau bắt đầu
·Đi phân có máu đỏ tươi khoảng một ngày sau đó do vi khuẩn sinh ra các chất độc làm tổn hại niêm mạc đường ruột
·Buồn nôn và nôn ói
·Sốt nhẹ
·Mệt mỏi , do mất nước và chất điện giải
Hình 2
Những triệu chứng trên thường dễ bị nhầm lẫn với các căn bệnh đường tiêu hóa khác. Do vậy nếu tự chuẩn đoán bệnh tại nhà thì rất dễ bị nhầm lẫn. Bạn nên tìm đến bệnh viện khám và làm xét nghiệm khi có các biểu hiện này để được chuẩn đoán chính xác bệnh và điều trị kịp thời. Vi khuẩn E.coli được biết đến là thủ phạm gây ra nhiều căn bệnh như:
·Tiêu chảy cấp: Phần lớn những người nhiễm vi khuẩn E.coli thường bị tiêu chảy đầu tiên. Người bệnh có biểu hiện đi phân nhày nước kèm theo máu. Tình trạng đau bụng, nôn mửa, sốt cao và mất nước cũng khó tránh khỏi khi bị tiêu chảy do nhiễm khuẩn E.coli
·Viêm đại tràng: Loại vi khuẩn này cũng được liệt kê vào danh sách các tác nhân gây ra bệnh viêm đại tràng. Chúng có thể khiến người bệnh bị rối loạn tiêu hóa, thường là tiêu chảy, đi ngoài ra máu và mất nước nghiêm trọng nếu không được phát hiện và điều trị kịp thời.
·Các bệnh lý khác: Vi khuẩn E.coli có khả năng di chuyển đến hệ tiết niệu hay xâm nhập vào trong máu và được truyền đi khắp cơ thể gây ra hàng loạt các căn bệnh như: Nhiễm trùng đường tiết niệu, viêm thận, viêm phổi, nhiễm trùng máu, viêm màng não…
Có thể thấy việc nhiễm vi khuẩn E.coli khá nguy hiểm và chúng ta không nên xem nhẹ công tác phòng ngừa loại vi khuẩn này lây lan thành dịch bệnh trong cộng đồng. Các chuyên gia y tế cho biết cách tốt nhất để phòng bệnh giữ gìn vệ sinh môi trường sống sạch sẽ; chỉ nên ăn các thức ăn đã được nấu chín, uống nước đun sôi để nguội và tuyệt đối không nên ăn các thức ăn không đảm bảo vệ sinh được bày bán ngoài lề đường. Thêm vào đó việc trang bị một số kiến thức cơ bản để biết được vi khuẩn E.coli là gì, các nguyên nhân gây nhiễm khuẩn E.coli và triệu chứng gặp phải khi bị nhiễm bệnh cũng có ý nghĩa rất quan trọng trong việc phòng ngừa và điều trị bệnh.

Hình 3
Nhằm cung cấp thêm các thông tin hữu ích trong quá trình nghiên cứu về các bệnh lý do E. coli gây nên, cũng như phương phức nghiên cứu về chẩn đoán và điều trị, chúng tôi xin chia sẻ một số tài liệu như sau:
1.The unexhausted potential of E. coli.Blount ZD.Elife. 2015 Mar 25;4. doi: 10.7554/eLife.05826. Review.PMID: 25807083 Free PMC Article Similar articles Select item 233842042.
2.Comparisons of infant Escherichia coli isolates link genomic profiles with adaptation to the ecological niche.de Muinck EJ, Lagesen K, Afset JE, Didelot X, Rønningen KS, Rudi K, Stenseth NC, Trosvik P.BMC Genomics. 2013 Feb 5;14:81. doi: 10.1186/1471-2164-14-81.PMID: 23384204 Free PMC Article Similar articles Select item 216762233.
3.Comparative genomics of Escherichia coli isolated from patients with inflammatory bowel disease.
4.Vejborg RM, Hancock V, Petersen AM, Krogfelt KA, Klemm P.BMC Genomics. 2011 Jun 15;12:316. doi: 10.1186/1471-2164-12-316.PMID: 21676223 Free PMC Article Similar articles Select item 233408014.
5.E. coli as an all-rounder: the thin line between commensalism and pathogenicity.Leimbach A, Hacker J, Dobrindt U.Curr Top Microbiol Immunol. 2013;358:3-32. doi: 10.1007/82_2012_303. Review.PMID: 23340801 Similar articles Select item 85194805.
6.Colonization factors of diarrheagenic E. coli and their intestinal receptors.Cassels FJ, Wolf MK.J Ind Microbiol. 1995 Sep;15(3):214-26. Review.PMID:8519480 Similar articles Select item 187908646.
7.Escherichia coli harboring a natural IncF conjugative F plasmid develops complex mature biofilms by stimulating synthesis of colanic acid and Curli.May T, Okabe S.J Bacteriol. 2008 Nov;190(22):7479-90. doi: 10.1128/JB.00823-08. Epub 2008 Sep 12.PMID: 18790864 Free PMC Article Similar articles Select item 205744587.

Hình 4
8.Survival of Escherichia coli in the environment: fundamental and public health aspects.van Elsas JD, Semenov AV, Costa R, Trevors JT.ISME J. 2011 Feb;5(2):173-83. doi: 10.1038/ismej.2010.80. Epub 2010 Jun 24. Review. Erratum in: ISME J. 2011 Feb;5(2):367. PMID: 20574458 Free PMC Article Similar articles Select item 270674098.
9.SuperPhy: predictive genomics for the bacterial pathogen Escherichia coli.Whiteside MD, Laing CR, Manji A, Kruczkiewicz P, Taboada EN, Gannon VP.BMC Microbiol. 2016 Apr 12;16:65. doi: 10.1186/s12866-016-0680-0.PMID: 27067409 Free PMC Article Similar articles Select item 162348659.
10.Effects of the twin-arginine translocase on the structure and antimicrobial susceptibility of Escherichia coli biofilms.Harrison JJ, Ceri H, Badry EA, Roper NJ, Tomlin KL, Turner RJ.Can J Microbiol. 2005 Aug;51(8):671-83.PMID: 16234865 Similar articles Select item 24568619.
11.Crowning: a novel Escherichia coli colonizing behaviour generating a self-organized corona.Gómez-Gómez JM, Amils R.BMC Res Notes. 2014 Feb 25;7:108. doi: 10.1186/1756-0500-7-108.PMID: 24568619 Free PMC Article Similar articles Select item 187738411.
12.Fate of recombinant Escherichia coli K-12 strains in the environment.Bogosian G, Kane JF.Adv Appl Microbiol. 1991;36:87-131. Review. No abstract available. PMID: 1877384 Similar articles Select item 609909012.
13.The population genetics of Escherichia coli.Hartl DL, Dykhuizen DE.Annu Rev Genet. 1984;18:31-68. Review.PMID: 6099090 Similar articles Select item 2580695913.
14.New opportunities at the wild frontier.Alfred J, Baldwin IT.Elife. 2015 Mar 25;4. doi: 10.7554/eLife.06956.PMID: 25806959 Free PMC Article Similar articles Select item 1476130614.

Hình 5
15.From the sequence to cell modeling: comprehensive functional genomics in Escherichia coli.Mori H.
16.J Biochem Mol Biol. 2004 Jan 31;37(1):83-92. Review.PMID: 14761306 Similar articles Select item 2456662115.
17.Escherichia coli pathotypes occupy distinct niches in the mouse intestine.Meador JP, Caldwell ME, Cohen PS, Conway T.Infect Immun. 2014 May;82(5):1931-8. doi: 10.1128/IAI.01435-13. Epub 2014 Feb 24. PMID: 24566621 Free PMC Article Similar articles Select item 2743818016.
18.The Resistome: A Comprehensive Database of Escherichia coli Resistance Phenotypes.Winkler JD, Halweg-Edwards AL, Erickson KE, Choudhury A, Pines G, Gill RT.ACS Synth Biol. 2016 Dec 16;5(12):1566-1577. Epub 2016 Aug 2.PMID: 27438180 Similar articles Select item 2334977317.
19.Nutritional basis for colonization resistance by human commensal Escherichia coli strains HS and Nissle 1917 against E. coli O157:H7 in the mouse intestine.Maltby R, Leatham-Jensen MP, Gibson T, Cohen PS, Conway T.PLoS one. 2013;8(1):e53957. doi: 10.1371/journal.pone.0053957. Epub 2013 Jan 17.PMID: 23349773 Free PMC Article Similar articles Select item 1916874418.
20.Role of deoxyribose catabolism in colonization of the murine intestine by pathogenic Escherichia coli strains.Martinez-Jéhanne V, du Merle L, Bernier-Fébreau C, Usein C, Gassama-Sow A, Wane AA, Gouali M, Damian M, Aïdara-Kane A, Germani Y, Fontanet A, Coddeville B, Guérardel Y, Le Bouguénec C.Infect Immun. 2009 Apr;77(4):1442-50. doi: 10.1128/IAI.01039-08. Epub 2009 Jan 21.PMID: 19168744 Free PMC Article Similar articles Select item 2011038819.
21.Probiotic Escherichia coli strain Nissle 1917 outcompetes intestinal pathogens during biofilm formation.Hancock V, Dahl M, Klemm P.J Med Microbiol. 2010 Apr;59(Pt 4):392-9. doi: 10.1099/jmm.0.008672-0. Epub 2010 Jan 28.PMID: 20110388 Similar articles Select item 2366744320.
22.Identification of commensal Escherichia coli genes involved in biofilm resistance to pathogen colonization.Da Re S, Valle J, Charbonnel N, Beloin C, Latour-Lambert P, Faure P, Turlin E, Le Bouguénec C, Renauld-Mongénie G, Forestier C, Ghigo JM.PLoS one. 2013 May 7;8(5):e61628. doi: 10.1371/journal.pone.0061628. Print 2013.PMID: 23667443 Free PMC Article Similar articles
23.Biocide resistance of Candida and Escherichia coli biofilms is associated with higher antioxidative capacities.Leung CY, Chan YC, Samaranayake LP, Seneviratne CJ.J Hosp Infect. 2012 Jun;81(2):79-86. doi: 10.1016/j.jhin.2011.09.014. Epub 2012 May 16. PMID: 22595316 Similar articles Select item 2226624122.

Hình 7
25.The evolution of the Escherichia coli phylogeny.Chaudhuri RR, Henderson IR.Infect Genet Evol. 2012 Mar;12(2):214-26. doi: 10.1016/j.meegid.2012.01.005. Epub 2012 Jan 14. Review.PMID: 22266241 Similar articles Select item 2508305023.
26.Escherichia coli-host macrophage interactions in the pathogenesis of inflammatory bowel disease.Tawfik A, Flanagan PK, Campbell BJ.World J Gastroenterol. 2014 Jul 21;20(27):8751-63. doi: 10.3748/wjg.v20.i27.8751. Review.PMID: 25083050 Free PMC Article Similar articles Select item 2688567624.
27.The interplay of Escherichia coli O157:H7 and commensal E. coli: the importance of strain-level identification.Figler HM, Dudley EG.Expert Rev Gastroenterol Hepatol. 2016;10(4):415-7. doi: 10.1586/17474124.2016.1155449. Epub 2016 Mar 7. Review. No abstract available. PMID: 26885676 Similar articles Select item 2239292825.
28.The streptomycin-treated mouse intestine selects Escherichia coli envZ missense mutants that interact with dense and diverse intestinal microbiota.Leatham-Jensen MP, Frimodt-Møller J, Adediran J, Mokszycki ME, Banner ME, Caughron JE, Krogfelt KA, Conway T, Cohen PS.Infect Immun. 2012 May;80(5):1716-27. doi: 10.1128/IAI.06193-11. Epub 2012 Mar 5.PMID: 22392928 Free PMC Article Similar articles Select item 2341400026.
29.High temporal variability in commensal Escherichia coli strain communities of a herbivorous marsupial.Blyton MD, Banks SC, Peakall R, Gordon DM.Environ Microbiol. 2013 Aug;15(8):2162-72. doi: 10.1111/1462-2920.12088. Epub 2013 Feb 17.PMID: 23414000 Similar articles Select item 1715400427.
30.Intestinal versus external growth conditions change the surficial properties in a collection of environmental Escherichia coli isolates.Yang HH, Morrow JB, Grasso D, Vinopal RT, Smets BF.Environ Sci Technol. 2006 Nov 15;40(22):6976-82. PMID: 17154004 Similar articles Select item 1899703028.

Hình 8
31.Intestine and environment of the chicken as reservoirs for extraintestinal pathogenic Escherichia coli strains with zoonotic potential.Ewers C, Antão EM, Diehl I, Philipp HC, Wieler LH.Appl Environ Microbiol. 2009 Jan;75(1):184-92. doi: 10.1128/AEM.01324-08. Epub 2008 Nov 7.PMID: 18997030 Free PMC Article Similar articles Select item 1071753529.
32.In vivo interactions of rabbit enteropathogenic Escherichia coli O103 with its host: an electron microscopic and histopathologic study.Heczko U, Abe A, Finlay BB.Microbes Infect. 2000 Jan;2(1):5-16. PMID: 10717535 Similar articles Select item 1760005030.
33.Comparative genomic hybridization and physiological characterization of environmental isolates indicate that significant (eco-)physiological properties are highly conserved in the species Escherichia coli. Ihssen J, Grasselli E, Bassin C, François P, Piffaretti JC, Köster W, Schrenzel J, Egli T. Microbiology. 2007 Jul;153(Pt 7):2052-66. PMID: 17600050 Similar articles Select item 871923031.
34.Natural infection with attaching and effacing Escherichia coli (O 103:H-) in chicks.Fukui H, Sueyoshi M, Haritani M, Nakazawa M, Naitoh S, Tani H, Uda Y.Avian Dis. 1995 Oct-Dec;39(4):912-8. PMID: 8719230 Similar articles Select item 1750191432.

Hình 9
35.Laboratory strains of Escherichia coli: model citizens or deceitful delinquents growing old disgracefully?Hobman JL, Penn CW, Pallen MJ.Mol Microbiol. 2007 May;64(4):881-5.PMID: 17501914 Free Article Similar articles Select item 265829433.
36.Natural infection with an attaching and effacing Escherichia coli in the small and large intestines of a calf with diarrhoea.Pearson GR, Watson CA, Hall GA, Wray C.Vet Rec. 1989 Mar 25;124(12):297-9.PMID: 2658294 Similar articles Select item 1145085434.
37.Environmental and food safety aspects of Escherichia coli O157:H7 infections in cattle.Rasmussen MA, Casey TA.Crit Rev Microbiol. 2001;27(2):57-73. Review.PMID: 11450854 Similar articles Select item 2773663835.

Hình 10
38.Enterococcus faecalis: E. coli's Siderophore-Inducing Sidekick.Hughes ER, Winter SE.Cell Host Microbe. 2016 Oct 12;20(4):411-412. doi: 10.1016/j.chom.2016.09.018.PMID: 27736638 Free PMC Article Similar articles Select item 388363636.
39.Scanning and transmission electron microscopy of attaching effacing Escherichia coli in weanling rabbits.Peeters JE, Charlier GJ, Raeymaekers R.Vet Pathol. 1985 Jan;22(1):54-9.PMID: 3883636 Similar articles Select item 1938371237.
40.Cellular chain formation in Escherichia coli biofilms.Vejborg RM, Klemm P.Microbiology. 2009 May;155(Pt 5):1407-17. doi: 10.1099/mic.0.026419-0. Epub 2009 Apr 21.PMID: 19383712 Similar articles Select item 2088635638.
41.Functional genomics of probiotic Escherichia coli Nissle 1917 and 83972, and UPEC strain CFT073: comparison of transcriptomes, growth and biofilm formation.Hancock V, Vejborg RM, Klemm P.Mol Genet Genomics. 2010 Dec;284(6):437-54. doi: 10.1007/s00438-010-0578-8. Epub 2010 Oct 1.PMID: 20886356 Similar articles Select item 2395890439.
42.The micronutrient zinc inhibits EAEC strain 042 adherence, biofilm formation, virulence gene expression, and epithelial cytokine responses benefiting the infected host.Medeiros P, Bolick DT, Roche JK, Noronha F, Pinheiro C, Kolling GL, Lima A, Guerrant RL.Virulence. 2013 Oct 1;4(7):624-33. doi: 10.4161/viru.26120. Epub 2013 Aug 19.PMID: 23958904 Free PMC Article Similar articles Select item 2519872540.
43.Pseudomonas aeruginosa promotes Escherichia coli biofilm formation in nutrient-limited medium.Culotti A, Packman AI.PLoS one. 2014 Sep 8;9(9):e107186. doi: 10.1371/journal.pone.0107186. eCollection 2014.PMID: 25198725 Free PMC Article Similar articles
44.High-throughput microfluidic method to study biofilm formation and host-pathogen interactions in pathogenic Escherichia coli.Tremblay YD, Vogeleer P, Jacques M, Harel J.Appl Environ Microbiol. 2015 Apr;81(8):2827-40. doi: 10.1128/AEM.04208-14. Epub 2015 Feb 13.PMID: 25681176 Free PMC Article Similar articles Select item 1155456342.
45.Distribution of the outer membrane haem receptor protein ChuA in environmental and human isolates of Escherichia coli.Hoffmann H, Hornef MW, Schubert S, Roggenkamp A.Int J Med Microbiol. 2001 Aug;291(3):227-30.PMID: 11554563 Similar articles Select item 2436242243.
46.Potentially pathogenic Escherichia coli can form a biofilm under conditions relevant to the food production chain.Nesse LL, Sekse C, Berg K, Johannesen KC, Solheim H, Vestby LK, Urdahl AM.Appl Environ Microbiol. 2014 Apr;80(7):2042-9. doi: 10.1128/AEM.03331-13. Epub 2013 Dec 20. PMID: 24362422 Free PMC Article Similar articles Select item 1668979144.

Hình 11
47.Sex and virulence in Escherichia coli: an evolutionary perspective.Wirth T, Falush D, Lan R, Colles F, Mensa P, Wieler LH, Karch H, Reeves PR, Maiden MC, Ochman H, Achtman M.Mol Microbiol. 2006 Jun;60(5):1136-51.PMID: 16689791 Free PMC Article Similar articles Select item 2325958645.
48.Development of functionalised polyelectrolyte capsules using filamentous Escherichia coli cells.Lederer FL, Günther TJ, Weinert U, Raff J, Pollmann K.Microb Cell Fact. 2012 Dec 23;11:163. doi: 10.1186/1475-2859-11-163. PMID: 23259586 Free PMC Article Similar articles Select item 1640289146.

Hình 12
49.Proteogenomic approaches for the molecular characterization of natural microbial communities. Banfield JF, Verberkmoes NC, Hettich RL, Thelen MP.OMICS. 2005 Winter;9(4):301-33.PMID: 16402891 Similar articles Select item 2602469347.
50.The pathophysiological role of bacterial biofilms in chronic sinusitis.Dlugaszewska J, Leszczynska M, Lenkowski M, Tatarska A, Pastusiak T, Szyfter W.Eur Arch Otorhinolaryngol. 2016 Aug;273(8):1989-94. doi: 10.1007/s00405-015-3650-5. Epub 2015 May 30.PMID: 26024693 Free PMC Article Similar articles Select item 1766829548.
51.Insights into the biology of Escherichia coli through structural proteomics.Matte A, Jia Z, Sunita S, Sivaraman J, Cygler M.J Struct Funct Genomics. 2007 Sep;8(2-3):45-55. Epub 2007 Aug 1. Review.PMID: 17668295 Similar articles Select item 1966120849.
52.Escherichia coli and its lipopolysaccharide modulate in vitro Candida biofilm formation.Bandara HM, Yau JY, Watt RM, Jin LJ, Samaranayake LP.J Med Microbiol. 2009 Dec;58(Pt 12):1623-31. doi: 10.1099/jmm.0.012989-0. Epub 2009 Aug 6.PMID: 19661208 Similar articles Select item 2391280750.
53.Macromolecular crowding: chemistry and physics meet biology (Ascona, Switzerland, 10-14 June 2012).Foffi G, Pastore A, Piazza F, Temussi PA.Phys Biol. 2013 Aug 2;10(4):040301. [Epub ahead of print] PMID: 23912807 Similar articles Select item 2686747851.

Hình 12
54.The role of genomic islands in Escherichia coli K1 interactions with intestinal and kidney epithelial cells.Yousuf FA, Rafiq S, Siddiqui R, Khan NA.Microb Pathog. 2016 Apr;93:145-51. doi: 10.1016/j.micpath.2016.02.002. Epub 2016 Feb 8. PMID: 26867478 Similar articles Select item 1500677552.
55.High diversity among environmental Escherichia coli isolates from a bovine feedlot. Yang HH, Vinopal RT, Grasso D, Smets BF.Appl Environ Microbiol. 2004 Mar;70(3):1528-36. PMID: 15006775 Free PMC Article Similar articles Select item 2155843453.
56.Screening of Escherichia coli species biodiversity reveals new biofilm-associated antiadhesion polysaccharides. Rendueles O, Travier L, Latour-Lambert P, Fontaine T, Magnus J, Denamur E, Ghigo JM. MBio. 2011 May 10;2(3):e00043-11. doi: 10.1128/mBio.00043-11. Print 2011. PMID: 21558434 Free PMC Article Similar articles Select item 2349797954.

Hình 13
57.Roles of ionic strength and biofilm roughness on adhesion kinetics of Escherichia coli onto groundwater biofilm grown on PVC surfaces.Janjaroen D, Ling FQ, Monroy G, Derlon N, Morgenroth E, Boppart SA, Liu WT, Nguyen TH. Water Res. 2013 May 1;47(7):2531-42. doi: 10.1016/j.watres.2013.02.032. Epub 2013 Feb 26. Erratum in: Water Res. 2014 Feb 1;49:485. Ling, Fangqiong [corrected to Ling, Fangqiong Q]; Mogenroth, Eberhard [corrected to Morgenroth, Eberhard]. PMID: 23497979 Free PMC Article Similar articles Select item 2686909655.
58.Mechanisms of cephalosporin resistance in indicator Escherichia coli isolated from food animals. Lalak A, Wasyl D, Zając M, Skarżyńska M, Hoszowski A, Samcik I, Woźniakowski G, Szulowski K. Vet Microbiol. 2016 Oct 15;194:69-73. doi: 10.1016/j.vetmic.2016.01.023. Epub 2016 Feb 2. PMID: 26869096 Similar articles Select item 2604133356.
59.The secret lives of Drosophila flies. Markow TA.Elife. 2015 Jun 4;4. doi: 10.7554/eLife.06793. Review. PMID: 26041333 Free PMC Article Similar articles Select item 2580708657.
60.The fascinating and secret wild life of the budding yeast S. cerevisiae. Liti G. Elife. 2015 Mar 25;4. doi: 10.7554/eLife.05835. Review. PMID:25807086 Free PMC Article Similar articles Select item 2725674058.
61.[Population genomic researches of Escherichia coli]. Wu YR, Yang RF, Cui YJ. Zhonghua Yu Fang Yi Xue Za Zhi. 2016 Jun;50(6):554-8. doi: 10.3760/cma.j.issn.0253-9624.2016.06.017. Review. Chinese. PMID: 27256740 Similar articles Select item 2295889559.
62.A phylogenomic analysis of Escherichia coli / Shigella group: implications of genomic features associated with pathogenicity and ecological adaptation. Zhang Y, Lin K. BMC Evol Biol. 2012 Sep 7;12:174. doi: 10.1186/1471-2148-12-174. PMID: 22958895 Free PMC Article Similar articles Select item 2008585360.
63.Control of methicillin-resistant Staphylococcus aureus in planktonic form and biofilms: a biocidal efficacy study of nonthermal dielectric-barrier discharge plasma. Joshi SG, Paff M, Friedman G, Fridman G, Fridman A, Brooks AD. Am J Infect Control. 2010 May;38(4):293-301. doi: 10.1016/j.ajic.2009.11.002. Epub 2010 Jan 20. PMID: 20085853 Similar articles
64.High-throughput metal susceptibility testing of microbial biofilms. Harrison JJ, Turner RJ, Ceri H. BMC Microbiol. 2005 Oct 3;5:53. PMID:16202124 Free PMC Article Similar articles Select item 1878472462.
65.Understanding the limits to generalizability of experimental evolutionary models. Forde SE, Beardmore RE, Gudelj I, Arkin SS, Thompson JN, Hurst LD. Nature. 2008 Sep 11;455(7210):220-3. doi: 10.1038/nature07152. PMID: 18784724 Similar articles Select item 2478367363.

Hình 14
66.Bridging the lab-field divide? The "eco" in ecological genomics. van der Hout S. Hist Philos Life Sci. 2013;35(4):577-98. PMID: 24783673 Similar articles Select item 1526523764.
67.Characterization of the GATC regulatory network in E. coli. Riva A, Delorme MO, Chevalier T, Guilhot N, Hénaut C, Hénaut A. BMC Genomics. 2004 Jul 20;5(1):48. PMID: 15265237 Free PMC Article Similar articles Select item 2062571365.
68.Oral-derived bacterial flora defends its domain by recognizing and killing intruders--a molecular analysis using Escherichia coli as a model intestinal bacterium. He X, Tian Y, Guo L, Lux R, Zusman DR, Shi W. Microb Ecol. 2010 Oct;60(3):655-64. doi: 10.1007/s00248-010-9708-4. Epub 2010 Jul 13. PMID: 20625713 Free PMC Article Similar articles Select item 2618509066.
69.The Biology of the Escherichia coli Extracellular Matrix. Hufnagel DA, Depas WH, Chapman MR. Microbiol Spectr. 2015 Jun;3(3). doi: 10.1128/microbiolspec.MB-0014-2014. PMID: 26185090 Free PMC Article Similar articles Select item 1123493367.
70.Developmental pathway for biofilm formation in curli-producing Escherichia coli strains: role of flagella, curli and colanic acid. Prigent-Combaret C, Prensier G, Le Thi TT, Vidal O, Lejeune P, Dorel C. Environ Microbiol. 2000 Aug;2(4):450-64. PMID: 11234933 Similar articles Select item 2048331468.
71.Functional characterization of alternate optimal solutions of Escherichia coli's transcriptional and translational machinery. Thiele I, Fleming RM, Bordbar A, Schellenberger J, Palsson BØ. Biophys J. 2010 May 19;98(10):2072-81. doi: 10.1016/j.bpj.2010.01.060. PMID: 20483314 Free PMC Article Similar articles Select item 1947360969.
72.Biofilm formation by Escherichia coli isolated from patients with urinary tract infections. Salo J, Sevander JJ, Tapiainen T, Ikäheimo I, Pokka T, Koskela M, Uhari M. Clin Nephrol. 2009 May;71(5):501-7. PMID: 19473609 Similar articles Select item 1623801370.
73.(Patho-)Genomics of Escherichia coli. Dobrindt U. Int J Med Microbiol. 2005 Oct;295(6-7):357-71. Review. PMID: 16238013 Similar articles Select item 1714075071.
74.Contribution of AIDA-I to the pathogenicity of a porcine diarrheagenic Escherichia coli and to intestinal colonization through biofilm formation in pigs. Ravi M, Ngeleka M, Kim SH, Gyles C, Berthiaume F, Mourez M, Middleton D, Simko E. Vet Microbiol. 2007 Mar 10;120(3-4):308-19. Epub 2006 Nov 30. PMID: 17140750 Similar articles Select item 2557317772.
75.Giardia duodenalis-induced alterations of commensal bacteria kill Caenorhabditis elegans: a new model to study microbial-microbial interactions in the gut. Gerbaba TK, Gupta P, Rioux K, Hansen D, Buret AG. Am J Physiol Gastrointest Liver Physiol. 2015 Mar 15;308(6):G550-61. doi: 10.1152/ajpgi.00335.2014. Epub 2015 Jan 8. PMID: 25573177 Free PMC Article Similar articles Select item 1575750973.

Hình 16
76.Gene fusions and gene duplications: relevance to genomic annotation and functional analysis. Serres MH, Riley M. BMC Genomics. 2005 Mar 9;6:33. PMID: 15757509 Free PMC Article Similar articles Select item 2403391374.
77.Comparative genomics and transcriptomics analysis of experimentally evolved Escherichia coli MC1000 in complex environments. Puentes-Téllez PE, Kovács ÁT, Kuipers OP, van Elsas JD. Environ Microbiol. 2014 Mar;16(3):856-70. doi: 10.1111/1462-2920.12239. Epub 2013 Aug 27. PMID: 24033913 Similar articles Select item 1928297775.
78.Genome-scale reconstruction of Escherichia coli's transcriptional and translational machinery: a knowledge base, its mathematical formulation, and its functional characterization. Thiele I, Jamshidi N, Fleming RM, Palsson BØ. PLoS Comput Biol. 2009 Mar;5(3):e1000312. doi: 10.1371/journal.pcbi.1000312. Epub 2009 Mar 13. PMID: 19282977 Free PMC Article Similar articles Select item 2539758076.
79.Comparative genomic analysis shows that avian pathogenic Escherichia coli isolate IMT5155 (O2:K1:H5; ST complex 95, ST140) shares close relationship with ST95 APEC O1:K1 and human ExPEC O18:K1 strains. Zhu Ge X, Jiang J, Pan Z, Hu L, Wang S, Wang H, Leung FC, Dai J, Fan H. PLoS one. 2014 Nov 14;9(11):e112048. doi: 10.1371/journal.pone.0112048. eCollection 2014. PMID: 25397580 Free PMC Article Similar articles Select item 2296142077.
80.Growth and characterization of Escherichia coli DH5α biofilm on concrete surfaces as a protective layer against microbiologically influenced concrete deterioration (MICD). Soleimani S, Ormeci B, Isgor OB. Appl Microbiol Biotechnol. 2013 Feb;97(3):1093-102. doi: 10.1007/s00253-012-4379-3. Epub 2012 Sep 9. PMID: 22961420 Similar articles Select item 2224555378.
81.After genomics, what proteomics tools could help us understand the antimicrobial resistance of Escherichia coli?; Radhouani H, Pinto L, Poeta P, Igrejas G. J Proteomics. 2012 Jun 6;75(10):2773-89. doi: 10.1016/j.jprot.2011.12.035. Epub 2012 Jan 5. Review.; PMID: 22245553 Similar articles Select item 1269504579.
82.Interaction with avian cells and colonisation of specific pathogen free chicks by Shiga-toxin negative Escherichia coli O157:H7 (NCTC 12900). Best A, La Ragione RM, Cooley WA, O'Connor CD, Velge P, Woodward MJ. Vet Microbiol. 2003 May 29;93(3):207-22. PMID: 12695045 Similar articles Select item 1123898880.
83.Escherichia coli and Salmonella 2000: the view from here. Schaechter M; View From Here Group. Microbiol Mol Biol Rev. 2001 Mar;65(1):119-30. Review. PMID: 11238988 Free PMC Article Similar articles
84.High-throughput metal susceptibility testing of microbial biofilms. Harrison JJ, Turner RJ, Ceri H. BMC Microbiol. 2005 Oct 3;5:53. PMID: 16202124 Free PMC Article Similar articles Select item 1878472462.
85.Understanding the limits to generalizability of experimental evolutionary models. Forde SE, Beardmore RE, Gudelj I, Arkin SS, Thompson JN, Hurst LD. Nature. 2008 Sep 11;455(7210):220-3. doi: 10.1038/nature07152. PMID: 18784724 Similar articles Select item 2478367363.
86.Bridging the lab-field divide? The "eco" in ecological genomics. van der Hout S. Hist Philos Life Sci. 2013;35(4):577-98. PMID: 24783673 Similar articles Select item 1526523764.
87.Characterization of the GATC regulatory network in E. coli. Riva A, Delorme MO, Chevalier T, Guilhot N, Hénaut C, Hénaut A. BMC Genomics. 2004 Jul 20;5(1):48. PMID: 15265237 Free PMC Article Similar articles Select item 2062571365.
88.Oral-derived bacterial flora defends its domain by recognizing and killing intruders--a molecular analysis using Escherichia coli as a model intestinal bacterium. He X, Tian Y, Guo L, Lux R, Zusman DR, Shi W. Microb Ecol. 2010 Oct;60(3):655-64. doi: 10.1007/s00248-010-9708-4. Epub 2010 Jul 13. PMID: 20625713 Free PMC Article Similar articles Select item 2618509066.